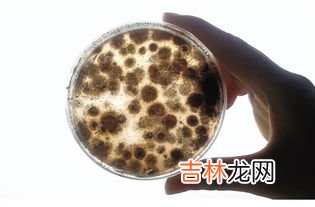

1、细菌需要有空气吗?不一定 , 有的细菌需要空气中的氧繁殖叫需氧菌 , 有的细菌不需要空气中的氧繁殖叫厌氧菌 。
常见需要空气中的氧繁殖的细菌有,主要是需氧菌,有脑膜炎奈瑟氏菌、结核杆菌、溶血性球菌、白喉杆菌、百日咳杆菌等 。这些细菌有完善的呼吸酶系统,需分子氧做受氢体,在有氧条件下才能生殖繁殖 。
常见不需要空气中的氧繁殖的细菌有,多数是厌氧菌,如脆弱类杆菌、腐蚀类杆菌、核梭杆菌、坏死梭杆菌、痤疮丙酸杆菌、乳酸杆菌等 。厌氧消化链球菌、破伤风梭菌、诺维梭菌等,这些细菌没有完善的呼吸酶系统,只能在无氧条件下才能生殖繁殖 。
细菌简介
细菌的个体非常小 , 目前已知最小的细菌只有0点2微米长,因此大多只能在显微镜下被看到,细菌一般是单细胞,细胞结构简单,缺乏细胞核、细胞骨架以及膜状胞器 , 例如线粒体和叶绿体,基于这些特征,细菌属于原核生物 。
原核生物中还有另一类生物称作古细菌,是科学家依据演化关系而另辟的类别,为了区别,本类生物也被称为真细菌,细菌广泛分布于土壤和水中,或者与其他生物共生,人体身上也带有相当多的细菌 。据估计,人体内及表皮上的细菌细胞总数约是人体细胞总数的十倍 。
此外,也有部分种类分布在极端的环境中,例如温泉,甚至是放射性废弃物中 , 它们被归类为嗜极生物,其中最著名的种类之一是海栖热袍菌,科学家是在意大利的一座海底火山中发现这种细菌的 。然而,细菌的种类是如此之多,科学家研究过并命名的种类只占其中的小部分 。
细菌域下所有门中 , 只有约一半是能在实验室培养的种类,细菌的营养方式有自养及异养,其中异养的腐生细菌是生态系中重要的分解者,使碳循环能顺利进行,部分细菌会进行固氮作用,使氮元素得以转换为生物能利用的形式 。
细菌也对人类活动有很大的影响,一方面,细菌是许多疾病的病原体 , 包括肺结核、淋病、炭疽病、梅毒、鼠疫、砂眼等疾病都是由细菌所引发,然而,人类也时常利用细菌,例如乳酪及酸奶的制作、部分抗生素的制造及废水的处理等,都与细菌有关 。
在生物科技领域中,细菌也有着广泛的运用 , 细菌是一种单细胞生物体,生物学家把这种生物归入裂殖菌类 , 细菌细胞的细胞壁非常像普通植物细胞的细胞壁,但没有叶绿素,因此,细菌往往与其他缺乏叶绿素的植物结成团块,并被看作真菌 。
大部分细菌是分解者,处在生物链的最底层,还有一部分细菌是消费者和生产者,比如硫细菌,铁细菌等,他们是化能合成异养型,属于生产者,可以利用无机物硫铁等制造自身需要的有机物 。而根瘤菌则是消费者 。
它们与豆科植物互利共生,消耗豆科植物光合作用所生产的有机物,因此为消费者 , 当然,细菌最主要的作用还是分解者,如果没有细菌真菌等微生物,世界将是尸体的海洋 。
文章插图
文章插图
2、细菌也需要空气吗不一定,有的细菌要有氧呼吸才能生存,而有的细菌需要无氧才能生存 。例如需要空气中的氧繁殖的细菌有结核杆菌、溶血性球菌、白喉杆菌等 。而不需要空气中的氧繁殖的细菌有脆弱类杆菌、腐蚀类杆菌、核梭杆菌、乳酸杆菌等 。
不一定,有的细菌要有氧呼吸才能生存,而有的细菌需要无氧才能生存 。例如需要空气中的氧繁殖的细菌有结核杆菌、溶血性球菌、白喉杆菌等 。而不需要空气中的氧繁殖的细菌有脆弱类杆菌、腐蚀类杆菌、核梭杆菌、乳酸杆菌等 。
经验总结扩展阅读
- 转乘车应该如何坐,坐火车中途要转车,需不需要出站,怎么转,急急急!!!
- 用清水洗筷子等于吃细菌,每天用清水洗筷子可以洗掉细菌吗?正确的做法是什么?
- 脏橘色需要漂色吗,底色在染发里面是什么意思?我的头发是奶茶棕,如果我想染脏橘色需不需要褪色鸭?
- 炸牛扒的方法,牛排可以用空气炸锅么
- 空气炸锅可以直接抽出来吗,空气炸锅可以中途拉出来吗,空气炸锅运行中可以拉出来吗
- 压缩气罐是干嘛的,压缩空气罐的使用和注意事项
- 孩子睡觉磨牙需要看医生吗,宝宝磨牙到底需不需要看医生?
- 照身份证可以空气刘海么,拍身份证可以化妆吗?可以有刘海吗?
- 鲜人参泡酒需不需要洗了晾干,新鲜人参酒怎么泡制方法
- 瓷盘子可以放在空气炸锅里吗,瓷盘子可以放在空气炸锅里吗?